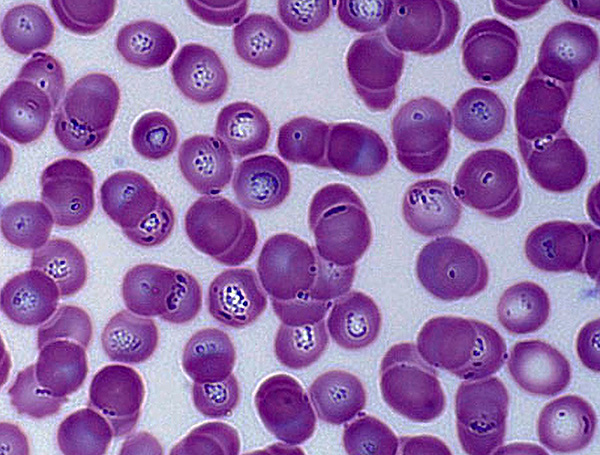
Voici à quoi ressemble le sang d'un chien atteint de piroplasmose au microscope - les piroplasmes sont clairement visibles dans les globules rouges.

Il est bien connu que les tiques peuvent être porteuses de maladies dangereuses pour l'homme. Mais une personne est souvent une victime accidentelle et non sa principale victime. Les tiques ixodides sont avant tout des parasites d'animaux sauvages, mais en cas de succès, elles ne dédaignent ni une personne ni ses animaux de compagnie.
De plus, ce sont les chiens qui sont particulièrement sensibles aux maladies transmises par les tiques, contrairement, par exemple, aux chats - et pas seulement parce que les chiens sont plus mobiles, aiment davantage jouer sur l'herbe et qu'il y a plus de races à poils longs parmi eux. Les caractéristiques du système immunitaire apportent également une contribution significative.
Voyons si les chiens souffrent d'encéphalite à tiques et en quoi cette maladie et les autres infections transmises par les tiques sont généralement dangereuses pour eux...
Un chien peut-il développer une encéphalite à tiques ?
L'encéphalite à tiques est une maladie qui peut avoir de graves conséquences chez l'homme. Elle est causée par un virus qui se multiplie dans les cellules du système nerveux central, causant souvent des dommages irréversibles et entraînant de graves conséquences pour la santé, une invalidité et parfois la mort. Il est à noter que les chiens ne sont pas autant sensibles à cette infection que les humains.

Dans le même temps, on ne peut pas considérer que la probabilité de développer cette maladie chez un chien est absolument exclue - plusieurs cas d'infection de chiens atteints d'encéphalite à tiques ont été décrits.Il existe également des rapports fiables sur la mort de chiens à cause de cette infection - et s'il arrivait que le chien tombe malade, le virus affectait très rapidement le cerveau, entraînant une paralysie et, par conséquent, la mort de l'animal. Mais ces cas sont très rares.
Sur une note
Seules 14 espèces peuvent être encéphalitiques tiques ixodides. Dans le même temps, Ixodes ricinus (tique du chien), et dans la zone de la taïga et en Asie - Ixodes persulcatus (tique de la taïga).
Les photos ci-dessous montrent à quoi ressemblent ces vecteurs d'encéphalite à tiques :
Ixodes ricin
Ixodes persulcatus
En général, vous n'avez pas à craindre qu'un chien tombe malade d'encéphalite à tiques après une morsure de tique, car la probabilité que cela soit extrêmement faible.
La principale raison d'une résistance aussi frappante des chiens au virus TBE est la spécificité du système immunitaire, qui est assez différent de celui de l'homme. Il est généralement admis que les chiens sont simplement physiologiquement immunisés contre le virus de l'encéphalite à tiques, et les rares cas de la maladie ne sont rien de plus qu'une exception qui n'est pas la norme et ne fait que confirmer la règle générale.
Cependant, les tiques peuvent infecter les chiens avec d'autres infections qui sont plus courantes que l'encéphalite à tiques chez l'homme et plus dangereuses spécifiquement pour les chiens en raison de la fréquence plus élevée des décès. De plus, le mot "encéphalite" lui-même fait référence à une réaction inflammatoire dans le cerveau, et une telle inflammation peut se développer chez un chien lorsqu'il est infecté par des infections de nature bactérienne transmises par les tiques.
En termes simples, les chiens sont rarement infectés par l'encéphalite transmise par les tiques, mais beaucoup plus souvent que les humains, ils sont infectés par d'autres infections de ces parasites, et non moins dangereuses.
Les infections à tiques les plus dangereuses pour les chiens
Parmi les maladies transmises par les tiques qui peuvent être compliquées par de graves lésions du système nerveux central chez les chiens, l'une des plus courantes et des plus dangereuses pour eux est la piroplasmose. Un autre nom pour cette maladie est la babésiose.
Au cours d'une morsure, avec la salive d'une tique, des agents infectieux - protozoaires - parasites des globules rouges - les soi-disant piroplasmes, pénètrent également dans le corps de l'animal. Ils peuvent également être trouvés dans d'autres composants sanguins, mais moins fréquemment.
Dans chaque érythrocyte affecté, en moyenne, 2 piroplasmes se déposent généralement, mais leur nombre peut atteindre sept. Et dans certains cas, il existe des parasites uniques géants qui occupent tout le globule rouge dans son ensemble. Ces micro-organismes dans leurs lieux d'accumulation détruisent les structures cellulaires des cellules sanguines, et puisque les érythrocytes sont responsables du transport de l'oxygène des poumons vers tous les organes et tissus de l'animal, s'ils sont endommagés, le chien commence à souffrir d'un manque d'oxygène , il développe rapidement une anémie.
De plus, les agents étrangers eux-mêmes provoquent une cascade de réactions immunitaires graves, provoquant des processus inflammatoires dans le corps. Le premier signe de piroplasmose aiguë est une forte augmentation de la température à 41-42 degrés. Dans ce cas, le chien devient léthargique, apathique, déprimé. La peau et les muqueuses pâlissent à cause de l'anémie, parfois jaunissent. Le deuxième ou le troisième jour de la maladie, l'urine de l'animal devient très sombre - les reins ne peuvent pas supporter la charge avec un manque d'oxygène, et les éléments sanguins et les pigments biliaires pénètrent dans les sécrétions.
Si l'animal n'est pas traité ou traité trop tard, des dommages au système nerveux apparaissent.Elles débutent par une faiblesse des membres postérieurs, puis se transforment en paralysie et se terminent par la mort de l'animal au troisième ou cinquième jour de maladie. Cependant, si vous contactez le vétérinaire en temps opportun, il y a toutes les chances de guérir complètement le chien et sans conséquences graves.

Extrêmement rare, mais il y avait des précédents où il ne s'écoulait que quelques heures entre l'apparition des premiers maux chez un animal et sa mort. On pense que cela est dû à la sensibilité particulière à la maladie de certains individus. Une évolution aussi rapide de la maladie est particulièrement caractéristique des chiots.
Il existe également des cas inverses, lorsque le chien présente des symptômes bénins périodiques de la maladie, suivis d'un état normal. Cela ne signifie pas que l'animal a vaincu l'infection. La force de l'immunité est suffisante pour empêcher la maladie de se développer pleinement - s'il y a une détérioration du bien-être semblable à une vague, cela indique une infection lente. Avec cette forme de la maladie, le système immunitaire est fortement sollicité, ce qui pourrait à l'avenir se manifester sous la forme d'allergies et de réactions auto-immunes. Par conséquent, si quelque chose vous a fait suspecter une forme chronique de piroplasmose, une consultation vétérinaire s'impose.
Sur une note
La piroplasmose est courante dans toute l'Eurasie, et l'infection d'un chien peut survenir à la fois dans la nature et sur un terrain personnel et même dans la ville. La zone d'infection s'étend. Aujourd'hui, il y a des épidémies massives de piroplasmose chez les chiens et, dans les foyers, la mortalité peut atteindre 22 à 24%.
Une autre maladie courante dangereuse pour l'homme est la borréliose de Lyme.Chez le chien, dans la grande majorité des cas, on observe une forme chronique de cette maladie, et l'animal peut être porteur de l'infection pendant des mois et des années.
L'infection par la borréliose transmise par les tiques se produit par les piqûres de tiques ixodides. L'agent causal est constitué de micro-organismes du genre Borrelia, qui ont une forme allongée en spirale torsadée. Borrelia parasite dans divers organes et tissus, grâce à quoi les manifestations de la borréliose peuvent être très diverses.

Borrelia burgdorferi - l'agent causal de la borréliose de Lyme
Dans le cas classique, les chiens sont le plus souvent touchés par le système musculo-squelettique, à savoir les articulations. Les symptômes locaux commencent à se propager progressivement à partir du site de la morsure, où Borrelia se reproduit, dans tout le corps, affectant des zones de plus en plus vastes. Le chien peut montrer de la léthargie, dormir plus souvent, commence à boiter en marchant. C'est un signe certain d'arthrite et un signal que vous devez consulter de toute urgence un vétérinaire.
Parfois, la borréliose affecte le muscle cardiaque, provoquant une tachycardie et d'autres problèmes avec le système cardiovasculaire chez le chien. Des lésions rénales se produisent également - Borrelia provoque une inflammation aiguë des organes excréteurs - en particulier une néphrite infectieuse.
La borréliose peut également provoquer une encéphalite - pénétrant dans le système nerveux, Borrelia affecte les méninges et les cellules nerveuses.
La difficulté pour le spécialiste est de différencier la maladie de Lyme de maladies de nature différente. Souvent, les décès surviennent précisément à cause d'un diagnostic erroné. Néanmoins, les chiens meurent rarement de borréliose, mais en cas de lésions graves du système nerveux, une issue fatale n'est en aucun cas exclue.
Sur une note
Il n'est pas rare qu'un chien présente de nombreux symptômes différents caractéristiques de plusieurs maladies. En effet, souvent lorsqu'une tique pique, elle transmet plusieurs infections au chien à la fois. La probabilité que cela soit particulièrement élevé si plusieurs parasites à longue alimentation ont été retirés de l'animal en même temps.
Quoi d'autre un animal de compagnie peut-il obtenir?
En plus de la piroplasmose et de la borréliose de Lyme, les tiques peuvent également être porteuses d'autres infections dangereuses pour les chiens.

Par exemple:
- La fièvre pourprée est une infection aiguë qui se manifeste par un ensemble de symptômes fébriles. La maladie est causée par la rickettsie - de minuscules micro-organismes, dont l'infection entraîne une forte augmentation de la température, l'apparition de taches rougeâtres sur le corps, une somnolence, un gonflement, une perte de coordination, des douleurs dans les muscles et les yeux. La fièvre est souvent accompagnée de conjonctivite avec hémorragies. Le sang pénètre également dans les sécrétions du chien. La maladie débute très rapidement et, sans traitement approprié, peut entraîner la mort de l'animal.
- L'ehrlichiose est une maladie qui appartient également à la rickettsiose. Ehrlichia parasite les monocytes sanguins et migre avec eux dans tout le corps. Une cible favorite de cette maladie est les ganglions lymphatiques, qui commencent à gonfler même au stade initial de la maladie. La température augmente également, un écoulement purulent des yeux est enregistré. Parfois, l'erlichia peut également pénétrer dans le système nerveux, qui souffre d'encéphalite. Cependant, cette maladie n'est généralement pas mortelle, bien qu'elle puisse causer beaucoup de problèmes au chien et à son propriétaire. Un chien est souvent infecté par l'ehrlichiose et la piroplasmose, car ils sont portés par les mêmes types de tiques ;
- L'hépatozoonose est la seule maladie de la liste qui ne se transmet pas par la piqûre d'un parasite, mais par l'ingestion accidentelle d'une tique par un animal de compagnie. Dans les intestins du chien, des parasites unicellulaires du genre Hepatozoon sont libérés, d'où ils se sont déjà répandus dans tout le corps. Dans le sang, on les trouve dans les corps blancs - les leucocytes. Il n'y a rien de caractéristique dans les symptômes - des signes infectieux généraux sont observés. Il est possible de différencier l'hépatozoonose uniquement à l'aide de méthodes de diagnostic modernes;
- La bartonellose est une maladie très fréquente chez les animaux de compagnie, plus fréquente chez les chats. Bartonella est une bactérie qui peut être transmise à un chien non seulement par les tiques, mais aussi par les puces, les mouches et les poux. Lorsqu'ils pénètrent dans la circulation sanguine, ces micro-organismes envahissent les érythrocytes, les obligeant à se coller (agglutination). Ainsi, chez les chiens malades, des saignements, des problèmes cardiaques, une anémie et une perte de poids sont enregistrés. Les symptômes varient d'un cas à l'autre et sont très individuels.
Que faire si un chien est mordu par une tique : premiers secours
Si une tique a été trouvée sur un animal de compagnie, la première étape consiste à enlever le parasite de la peau de l'animal. Il faut effectuer cette manipulation le plus rapidement possible (sans attendre plusieurs heures), mais en même temps ne pas s'agiter et ne pas paniquer.N'oubliez pas : si une tique a mordu, cela ne veut pas dire que le chien va tomber malade avec quelque chose.

Il convient de mentionner ici qu'il n'est pas nécessaire d'extraire brusquement une tique aspirée - son corps peut se détacher de la tête, qui restera dans la plaie et provoquera une suppuration. Appliquer de l'huile ou d'autres liquides sur une tique mordue est inefficace - cela peut tuer le parasite, mais cela ne le fera pas sortir de la plaie tout seul.
Il est préférable de retirer la tique avec des mouvements de torsion, en ramassant doucement dispositif spécial pour enlever les tiques, ou, dans les cas extrêmes, des pincettes, voire des clous.

Lors de l'élimination du parasite, il est conseillé d'utiliser des gants, surtout si la peau présente des égratignures ou tout autre dommage - la tique ne doit pas entrer en contact avec une peau éraflée. La plaie chez le chien doit absolument être traitée avec un antiseptique et, après la procédure d'extraction du parasite, lavez-vous les mains à l'eau et au savon.
Voir aussi l'article
Si nous parlons du danger d'infection, plusieurs facteurs sont importants ici : combien de tiques ont mordu le chien, combien de temps elles sont restées attachées et dans quelle région cela s'est produit.
Les agents infectieux pénètrent dans la circulation sanguine par la salive infectée, et donc plus les individus se sont attachés à l'animal et plus ils se sont nourris longtemps, plus la probabilité potentielle que le chien tombe malade est élevée.

Un autre aspect est la région où le fait de la morsure a eu lieu. Si une zone donnée est défavorable aux infections par les tiques, le pourcentage de tiques infectées y est relativement élevé.
À proprement parler, il est possible de savoir immédiatement après l'extraction du parasite s'il est porteur de l'infection. Pour cela, la tique est examinée en laboratoire, où en quelques heures, elle peut émettre une conclusion sur son statut. Cependant, une telle analyse des infections auxquelles les chiens sont sensibles n'est pas effectuée dans tous les laboratoires (ou plutôt, la plupart d'entre eux ne le sont pas).
Cependant, même la détection d'agents pathogènes dangereux dans une tique ne signifie pas que la maladie correspondante se développera. L'immunité de nombreux chiens leur permet d'éviter tout symptôme même lorsqu'ils sont infectés - chez beaucoup d'entre eux, l'agent pathogène dans le corps meurt rapidement.
Sur une note
Il y a une pratique pour les gens prévention d'urgence de l'encéphalite à tiques, qui peut être produit dans les premières heures, ou un jour après la morsure. Après avoir reçu une injection, une personne ne tombera pas malade même si une tique infectée attaque. Cependant, dans le cas d'infections dangereuses pour les chiens, de telles mesures préventives ne sont pas prises.
Ainsi, si un chien est mordu par une tique, vous n'avez pas besoin de courir immédiatement chez le médecin ou de porter le parasite pour analyse. Cependant, dans les jours suivants, il est important de surveiller attentivement l'état de l'animal et, si des signes d'infection apparaissent, contactez immédiatement le vétérinaire.
Quels sont les premiers signes d'une maladie ?
Immédiatement après une morsure de tique, aucun changement dans le bien-être de l'animal ne se produit généralement. Même si l'infection est transmise, elle a besoin de temps pour se manifester pleinement. La période d'incubation des infections transmises par les tiques chez le chien varie en moyenne d'une à trois semaines, mais parfois elle est réduite à 4-5 jours (dans de rares cas, elle peut être étendue à plusieurs mois, ce qui est typique de la borréliose, qui peut aller inaperçu pendant très longtemps puis se manifester soudainement sous une forme aiguë).
En règle générale, les maladies transmises par les tiques chez les chiens commencent brusquement - tout propriétaire attentif remarque immédiatement comment le comportement de l'animal change. Le chien devient léthargique, dort davantage, refuse de jouer et de manger. Il peut y avoir un essoufflement, un changement de démarche, un assombrissement de l'urine. Le premier symptôme le plus important est une augmentation de la température corporelle (voir aussi Symptômes pouvant apparaître chez un chien après une morsure de tique).

Dans ce cas (surtout si une piqûre de tique récente est connue), les meilleurs premiers soins sont de garder l'animal aussi calme que possible et de consulter un vétérinaire dès que possible.Les infections par les tiques sont très insidieuses - elles peuvent parfois disparaître d'elles-mêmes aussi rapidement qu'elles ont commencé. Mais dans d'autres cas, un traitement complexe en plusieurs étapes est nécessaire, sans lequel le chien mourra rapidement.
Sur une note
Les animaux pur-sang sont généralement plus difficiles à tolérer la piroplasmose et se rétablissent plus longtemps que leurs simples parents de la rue. Le risque de tomber malade est également plus élevé chez les petits chiens que chez les grands.
En général, si tout va bien avec le chien trois semaines après la piqûre de tique, on peut supposer que le risque de développer la maladie est déjà très faible. Cela signifie que soit la tique n'était pas contagieuse, soit l'infection n'est pas entrée dans le corps du chien, ou même après l'infection, la maladie ne s'est pas développée, car l'agent pathogène a été éliminé par le système immunitaire.

Important!
Aux premiers symptômes suspects, il est préférable d'emmener l'animal chez le vétérinaire dès que possible - certaines maladies peuvent se développer à un stade irréversible en quelques jours seulement, et le médecin peut tout simplement ne pas avoir le temps de sauver le chien.
Traitement de l'animal, si l'infection s'est produite
Les infections à tiques sont trop graves pour être tentées à la maison. Étant donné que les symptômes de différentes maladies sont similaires à bien des égards, seul un vétérinaire peut poser le bon diagnostic (y compris en analysant le sang de l'animal).
Le chien reste généralement sous surveillance dans une clinique vétérinaire hospitalière. Le spécialiste prescrira des médicaments efficaces au bon dosage, et c'est une étape très importante - les médicaments qui donnent des résultats dans la piroplasmose peuvent ne pas du tout aider avec la maladie de Lyme, c'est pourquoi un diagnostic correct est si important.Pour un non-spécialiste, pratiquement toutes les maladies transmises par les tiques ne peuvent être diagnostiquées visuellement.

La stratégie de traitement est déterminée en fonction de l'agent pathogène identifié. Lorsqu'il est affecté par la borrelia, ce sera un antibiotique qui tue les agents pathogènes, ainsi qu'un ensemble de médicaments qui améliorent l'état général du chien. Si, par exemple, Bartonella est détectée (il n'y a pas d'antibiotiques contre eux), alors le traitement devient symptomatique.
La maladie épuise l'animal, donc pour un rétablissement rapide, il a besoin d'un régime alimentaire complet mais épargnant. Pour cela, des suppléments nutritionnels spéciaux sont en cours de développement, saturés de substances utiles et adaptés spécifiquement à la récupération des animaux.
Une personne peut-elle contracter une encéphalite à tiques ou une autre infection par un chien ?
Les infections par les tiques ne sont pas transmises des chiens aux humains (ni aux animaux de compagnie). Une exception peut être l'infection des chiots dans le ventre d'une mère malade, mais dans ce cas, ils meurent presque toujours avant la naissance.

C'est intéressant
On sait avec certitude que les chats malades, en se grattant, peuvent transmettre la bartonellose à l'homme. Mais en ce qui concerne les chiens, pas un seul cas de ce type n'a été enregistré.
Ainsi, vous ne pouvez être infecté que par une tique infectée, vous ne devez donc pas avoir peur de contracter une infection de votre animal de compagnie. De plus, les gens sont généralement peu sensibles à certaines maladies dangereuses pour les chiens - tout d'abord, cela concerne la piroplasmose.
Sur une note
Malgré le fait qu'il est impossible d'attraper la maladie de votre animal de compagnie, il est tout à fait possible de l'attraper à partir d'une tique qui a été retirée négligemment d'un chien. Il existe des cas connus de borréliose, lorsque, lorsque le parasite a été accidentellement écrasé, les gens se sont infectés en se frottant simplement les yeux après cela.Par conséquent, il est toujours préférable de retirer la tique avec des gants et, immédiatement après l'avoir retirée, de se laver les mains à l'eau et au savon.
Prévention des infections
Vaccination a été la méthode la plus fiable de prévention des infections pour les humains pendant de nombreuses années, mais n'est pas largement utilisée pour les animaux de compagnie. La raison en est que l'immunité du chien n'est pas capable de stocker pendant longtemps des anticorps qui protègent contre les maladies transmises par les tiques. Dans la plupart des cas, le vaccin n'est efficace que pendant un ou deux mois, et le faire toutes les quelques semaines n'a tout simplement pas de sens.

En raison de la disponibilité limitée des vaccins chez les chiens, il est important de protéger votre animal par des mesures préventives et d'éviter les piqûres de tiques. Cela se fait à l'aide de moyens tels que divers colliers anti-tiques, des gouttes sur le garrot et des sprays. Tous contiennent des produits chimiques qui ont un effet dissuasif et destructeur sur les parasites (dont les puces).
De tels remèdes aident à réduire le risque de piqûres de tiques, mais ne peuvent garantir une protection à cent pour cent. Par conséquent, il est important d'inspecter votre animal après une promenade dans les parcs et les zones forestières. Alors, peut-être, il sera possible d'attraper la tique avant même qu'elle ait le temps de coller (les acariens mettent beaucoup de temps à choisir l'endroit le plus propice à une morsure). Chez les chiens, les zones derrière les oreilles, les oreillettes elles-mêmes, l'aine, les aisselles et les espaces entre les doigts sont particulièrement à risque d'être mordus. C'est dans ces endroits que l'on trouve le plus souvent les tiques.
Symptômes de la piroplasmose chez le chien





